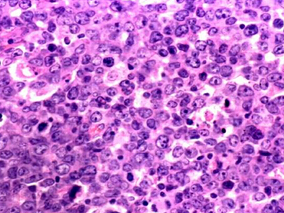
早期弥漫大B细胞淋巴瘤：化学免疫疗法和RIT是积极治疗方案

-
激素治疗能否改善卵巢癌存活率?
环球医学资讯
2015年10月15日
点击量:192
1小时条评论激素治疗(HT)能缓解更年期症状,但是缺乏关于它在绝经前卵巢癌幸存者中使用的共识。2015年8月,发表《Menopause.》的一项系统评价和荟萃分析表明,在接受HT治疗及对照女性中,包括当前系统评价在内的研究没有报告总体存活率和无病生存率的显著差异。 目的:激素治...
-
晚期肝癌患者:永久停用索拉非尼后生存率的预测因子
环球医学资讯
2015年10月12日
点击量:311
1小时条评论索拉非尼治疗晚期肝癌患者因肿瘤进展、肝功能失代偿或不良反应导致的预期停药而受到挑战。2015年9月,发表在《Hepatology》的一项前瞻性研究对晚期肝癌患者永久停用索拉非尼后生存率的预测因子进行研究。 索拉非尼治疗晚期肝癌患者因肿瘤进展、肝功能失代偿或不良反...
-
Elotuzumab可显著降低复发或难治性多发性骨髓瘤风险
环球医学资讯
2015年09月29日
点击量:250
1小时条评论Elotuzumab,一种免疫单克隆抗体,靶向信号淋巴细胞激活分子家族成员7。在一项1bndash;2期研究中表明与来那度胺和地塞米松联合治疗复发或难治性多发性骨髓瘤患者具有活性。2015年8月,发表在《N Engl J Med》的一项3期研究证实,接受elotuzumab、来那度胺和地塞米松...
-
转移性激素敏感性前列腺癌:ADT联合多西他赛治疗效…
环球医学资讯
2015年09月29日
点击量:331
1小时条评论雄性激素促进前列腺癌生长。雄激素去势疗法(ADT)一直是前列腺癌的标准治疗方案。虽然ADT是有效的,但是在大多数患者中,该疾病最终会对这种方案产生耐受。2015年8月,发表在《N Engl J Med》的一项研究表明,6个周期的多西他赛联合ADT治疗转移性前列腺癌比单独ADT...
-
伊鲁替尼+奥法木单抗治疗CLL优于伊鲁替尼单药
环球医学资讯
2015年09月25日
点击量:416
1小时条评论2015年8月,发表于《Blood》的一项研究评估了BTK抑制剂伊鲁替尼联合奥法木单抗治疗慢性淋巴细胞白血病的安全性和活性。结果显示,联合疗法比单独使用伊鲁替尼可以以更快的时间达到最好应答,且应答具有持续性。 nbsp; 伊鲁替尼使慢性淋巴细胞白血病(CLL)治疗取得...
-
中性粒细胞减少症伴血液恶性肿瘤患者能否接受高剂量…
环球医学资讯
2015年09月25日
点击量:375
1小时条评论头孢吡肟临床主要用于各种严重感染,如呼吸道感染、泌尿系统感染、胆道感染、败血症等。2015年9月发表在《Antimicrob Agents Chemother》的一项澳大利亚研究表明,发热性中性粒细胞减少症伴血液恶性肿瘤患者能够接受高剂量头孢吡肟治疗。 nbsp; 虽然指南推荐发热性...
-
早期弥漫大B细胞淋巴瘤:化学免疫疗法和RIT是积极治…
环球医学资讯
2015年09月25日
点击量:915
1小时条评论早期弥漫大B细胞淋巴瘤(DLBCL)患者一般会接受RCHOP单一疗法或联合牵涉区放疗(IFRT)。抗-CD20放射免疫治疗(RIT)对已知疾病范围外的微观部位有辐射作用。2015年9月,发表在《Br J Haematol.》的一项II期研究表明,化学免疫疗法和RIT对于早期DLBCL患者是一种积极...
-
复发或转移性头颈部鳞状细胞癌患者一线治疗方案的有…
环球医学资讯
2015年09月25日
点击量:263
1小时条评论手术、放疗和化疗是头颈部鳞癌的主要治疗手段。2015年9月发表在《Ann Oncol.》的一项法国和比利时科学家进行的研究,评估了复发或转移性头颈部鳞状细胞癌患者中,以西妥昔单抗联合多西他赛和顺铂作为一线治疗方案的有效性和安全性。结果显示,这种方案具有潜在有效性...
-
子宫内膜癌:口服避孕药可带来保护作用?
环球医学资讯
2015年09月24日
点击量:122
1小时条评论口服避孕药可以减少子宫内膜癌的发生率,但尚不确定停止使用后这种效果持续多久,或是否因受到其他因素影响而发生改变。2015年8月,发表在《Lancet Oncol.》的一项研究使用logistic回归评估子宫内膜癌相对风险(RR)与口服避孕药相关风险。结果表明,口服避孕药对子...
-
早期乳腺癌患者的治疗选择
环球医学资讯
2015年09月24日
点击量:292
1小时条评论2015年8月,发表在《Lancet Oncol.》的一项研究结果表明,向多西他赛+阿霉素+环磷酰胺方案中添加吉西他滨或卡培他滨对可手术的乳腺癌患者似乎未带来任何受益。贝伐珠单抗可改善总体生存率,与其他研究结果有冲突。 背景:NSABP b-40是一个3 times; 2析因试验检测...

会员登录

